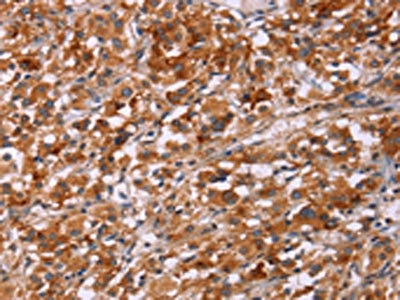

ICAM3 Antibody
-
中文名稱:ICAM3兔多克隆抗體
-
貨號:CSB-PA596032
-
規格:¥1100
-
圖片:
-
The image on the left is immunohistochemistry of paraffin-embedded Human gastic cancer tissue using CSB-PA596032(ICAM3 Antibody) at dilution 1/20, on the right is treated with synthetic peptide. (Original magnification: ×200)
-
The image on the left is immunohistochemistry of paraffin-embedded Human thyroid cancer tissue using CSB-PA596032(ICAM3 Antibody) at dilution 1/20, on the right is treated with synthetic peptide. (Original magnification: ×200)
-
Gel: 6%SDS-PAGE, Lysate: 40 μg, Lane: Jurkat cells, Primary antibody: CSB-PA596032(ICAM3 Antibody) at dilution 1/348, Secondary antibody: Goat anti rabbit IgG at 1/8000 dilution, Exposure time: 1 minute
-
-
其他:
產品詳情
-
Uniprot No.:
-
基因名:ICAM3
-
別名:ICAM3; Intercellular adhesion molecule 3; ICAM-3; CDw50; ICAM-R; CD antigen CD50
-
宿主:Rabbit
-
反應種屬:Human
-
免疫原:Synthetic peptide of Human ICAM3
-
免疫原種屬:Homo sapiens (Human)
-
標記方式:Non-conjugated
-
抗體亞型:IgG
-
純化方式:Antigen affinity purification
-
濃度:It differs from different batches. Please contact us to confirm it.
-
保存緩沖液:-20°C, pH7.4 PBS, 0.05% NaN3, 40% Glycerol
-
產品提供形式:Liquid
-
應用范圍:ELISA,WB,IHC
-
推薦稀釋比:
Application Recommended Dilution ELISA 1:1000-1:2000 WB 1:500-1:2000 IHC 1:25-1:100 -
Protocols:
-
儲存條件:Upon receipt, store at -20°C or -80°C. Avoid repeated freeze.
-
貨期:Basically, we can dispatch the products out in 1-3 working days after receiving your orders. Delivery time maybe differs from different purchasing way or location, please kindly consult your local distributors for specific delivery time.
-
用途:For Research Use Only. Not for use in diagnostic or therapeutic procedures.
相關產品
靶點詳情
-
功能:ICAM proteins are ligands for the leukocyte adhesion protein LFA-1 (integrin alpha-L/beta-2). ICAM3 is also a ligand for integrin alpha-D/beta-2. In association with integrin alpha-L/beta-2, contributes to apoptotic neutrophil phagocytosis by macrophages.
-
基因功能參考文獻:
- exploration of the underlying mechanism demonstrated that ICAM3 not only binds to LFA-1 with its extracellular domain and structure protein ERM but also to lamellipodia with its intracellular domain which causes a tension that pulls cells apart (metastasis). PMID: 29729315
- Increased expression of PECAM-1, ICAM-3, and VCAM-1 in colonic biopsies from patients with inflammatory bowel disease (IBD) in clinical remission is associated with subsequent flares; this suggests that increases in the expression of these proteins may be early events that lead to flares in patients with IBD PMID: 27552332
- ICAM3 acts as recognition receptors in the phagocytosis portals of macrophages for engulfment of apoptotic neutrophils. PMID: 23775590
- this data clearly indicate that ICAM-3 promotes drug resistance via inhibition of apoptosis. PMID: 24177012
- Intercellular adhesion molecule (ICAM)-3 mRNA is upregulated in non-adherent endothelial forming cells. PMID: 23144795
- Results indicate that the ICAM-3 gene promoter is negatively regulated by RUNX3. PMID: 22479382
- analysis of activated apoptotic cells induce dendritic cell maturation via engagement of Toll-like receptor 4 (TLR4), dendritic cell-specific intercellular adhesion molecule 3 (ICAM-3)-grabbing nonintegrin (DC-SIGN), and beta2 integrins PMID: 22396536
- ICAM-3 may be an important adhesion molecule involved in chemotaxis to apoptotic human leukocytes. PMID: 22117198
- the molecular basis of allergen-induced Th2 cell polarization PMID: 22205703
- the cross-talk between neutrophils and NK cells is mediated by ICAM-3 and CD11d/CD18, respectively. PMID: 21712539
- Single nucleotide polymorphisms in ICAM3 gene is associated with lymphoma. PMID: 21239057
- induction of morphological polarization in primary T lymphocytes and Jurkat cells enhances Kidins220/ARMS colocalization with ICAM-3 PMID: 21381019
- CCR1 antagonist, BX471, did not significantly alter ICAM-3 expression in relapsing-remitting multiple sclerosis patients. PMID: 20086017
- ICAM-3 enhances the migratory and invasive potential of human non-small cell lung cancer cells by inducing MMP-2 and MMP-9 via Akt and CREB PMID: 19956847
- no significant risk association was found for SARS infection for the ICAM-3 Asp143Gly SNP. PMID: 19801714
- A novel serine-rich motif in the intercellular adhesion molecule 3 is critical for its ezrin/radixin/moesin-directed subcellular targeting PMID: 11784723
- identification of DC-SIGN binding sites PMID: 11799126
- interactions with DC-SIGN does not promote DC-SIGN mediated HIV-1 transmission PMID: 12021323
- Expression of DC-SIGN and its ligand, ICAM-3, is found in substantial amounts only in RA synovium, suggesting that their interaction is implicated in the additional activation of synovial macrophages that leads to the production of EMMPRIN and MMP-1. PMID: 12571844
- ICAM-3 is highly expressed on the surface of human eosinophils and has a role in the downregulation of GM-CSF production. PMID: 12743567
- Relationship of intercellular adhesion molecule-3 and hepatocyte growth factor with amyloidosis A in chronic renal-failure patients. There was a higher density of intercellular adhesion molecule-3-positive cells in the patients with amyloidosis A. PMID: 14704632
- ICAM-3 is expressed on human bone marrow endothelial cells and controls endothelial integrity via reactive oxygen species-dependent signaling. PMID: 14726630
- acts as a costimulating molecule to increase HIV-1 transcription and viral replication, a process allowing productive infection of quiescent CD4+ T lymphocytes. PMID: 15163761
- Expression of ICAM-3 can be used as a valuable biomarker to predict the radiation resistance in cervical cancer that occurs during radiotherapy. PMID: 15880373
- The results suggest that ICAM-3 assists in the interaction of granulocytes with DC-SIGN of dendritic cells. PMID: 17145745
- Patients with SARS homozygous for ICAM3 Gly143 showed significant association with higher lactate dehydrogenase levels and lower total white blood cell counts. PMID: 17570115
- This is the first case of CD20 positive mycosis fungoides involving a lymph node to be reported in the literature. PMID: 18261116
- extended alpha(L)beta(2) with an open headpiece is required for ICAM-3 adhesion PMID: 18354203
顯示更多
收起更多
-
亞細胞定位:Membrane; Single-pass type I membrane protein.
-
蛋白家族:Immunoglobulin superfamily, ICAM family
-
組織特異性:Leukocytes.
-
數據庫鏈接:
Most popular with customers
-
-
YWHAB Recombinant Monoclonal Antibody
Applications: ELISA, WB, IHC, IF, FC
Species Reactivity: Human, Mouse, Rat
-
Phospho-YAP1 (S127) Recombinant Monoclonal Antibody
Applications: ELISA, WB, IHC
Species Reactivity: Human
-
-
-
-
-